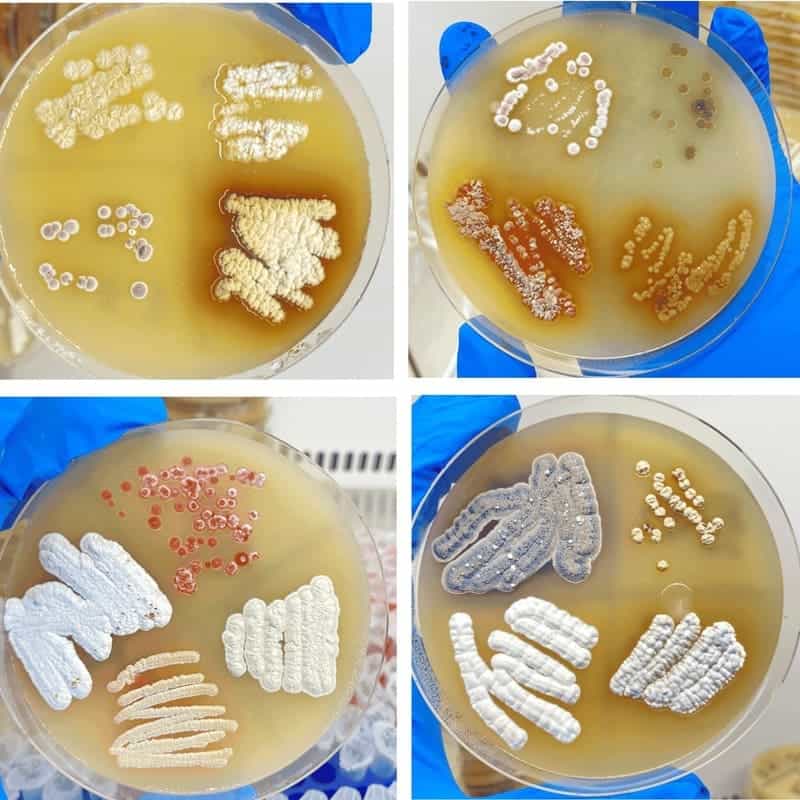

De plus en plus de maladies infectieuses deviennent résistantes aux médicaments actuels. Partant de ce constat, des chercheurs du collaboratoire Université Paris Cité-Inserm lancent un grand programme de recherche participative pour trouver de futurs médicaments grâce aux bactéries qui vivent dans les sols. Sous la coordination de Vincent Libis et Aude Bernheim de l’équipe de recherche Évolution et Ingénierie des Systèmes Dynamiques, dirigée par Ariel Lindner au Learning Planet Institute (Université Paris Cité, Inserm), chaque citoyen et citoyenne est invité à prendre part au projet Science à la Pelle et à recueillir des échantillons de terre tout au long de l’été 2022. Ces contributions concourront collectivement à faire avancer la recherche sur les médicaments pour lutter contre les maladies infectieuses.
De plus en plus de maladies infectieuses, causées par des bactéries ou virus pathogènes, deviennent résistantes aux médicaments actuels. Pourtant, ces maladies constituent une menace grandissante pour la santé humaine.
De nombreux médicaments utilisés aujourd’hui sont issus de molécules produites naturellement par les bactéries contenues dans les sols, mais seulement une infime portion de ces bactéries a été étudiée en laboratoire.
Pour faire avancer plus rapidement la recherche dans ce domaine, les chercheurs ont besoin de disposer d’une immense quantité de prélèvements de sols sur tout le territoire français et contenant potentiellement un grand nombre de bactéries à étudier pour l’intérêt thérapeutique qu’elles peuvent présenter.
C’est dans cette perspective que les chercheurs d’Université Paris Cité et de l’Inserm au sein du laboratoire Évolution et Ingénierie des Systèmes Dynamiques au Learning Planet Institute invitent les citoyens et citoyennes à rejoindre, cet été, le programme de recherche participative Science à la Pelle. Leur contribution, déterminante pour la réussite de ce projet de recherche, est simple. Durant leurs randonnées estivales, les participants sont invités à prélever une cuillère à soupe de terre de leur lieu de promenade, à envoyer l’échantillon aux chercheurs et à renseigner sur l’application disponible sur le site web du projet, les coordonnées et une photo du lieu de prélèvement.
L’équipe de recherche, qui a développé des méthodes de recherche innovantes permettant d’étudier à grande échelle ces bactéries, et d’identifier les molécules intéressantes qu’elles produisent, analysera tous les prélèvements reçus et présentera aux participants les résultats de leurs recherches.
Ce projet de recherche participative permettra aussi d’aborder des sujets comme les liens entre santé et biodiversité, l’antibiorésistance ou encore d’observer la fabuleuse variété du vivant qui vit dans les sols.
L’objectif du projet Science à la Pelle est de trouver, grâce aux bactéries qui vivent dans les sols, des médicaments efficaces contre les maladies infectieuses développant des résistances aux médicaments. La campagne s’étendra pendant tout l’été.
Contacts presse :
presse@u-paris.fr
presse@inserm.fr
Université Paris Cité : Université de recherche intensive pluridisciplinaire, labellisée «Initiative d’Excellence», Université Paris Cité se hisse au meilleur niveau international grâce à sa recherche, à la diversité de ses parcours de formation, à son soutien à l’innovation, et à sa participation active à la construction de l’espace européen de la recherche et de la formation. Université Paris Cité est composée de trois Facultés (Santé, Sciences et Sociétés et Humanités), d’un établissement-composante, l’Institut de physique du globe de Paris et d’un organisme de recherche partenaire, l’Institut Pasteur. Université Paris Cité compte 63 000 étudiants, 7 500 enseignants-chercheurs et chercheurs, 21 écoles doctorales et 119 unités de recherche. https://u-paris.fr
Inserm : Créé en 1964, l’Inserm est un établissement public à caractère scientifique et technologique, placé sous la double tutelle du ministère de la Santé et du ministère de la Recherche. L’Inserm est le seul organisme de recherche public français entièrement dédié à la santé humaine. Notre objectif : améliorer la santé de tous par le progrès des connaissances sur le vivant et sur les maladies et par l’innovation grâce à nos 300 unités de recherche et nos 150000 collaborateurs. Les échanges entre les chercheurs, les associations de patients, les groupements de professionnels du soin, les groupes d’accompagnement et plus largement la société civile, sont précieux pour l’Inserm. Le renforcement de l’engagement de l’Institut dans la recherche participative est inscrit dans son plan stratégique.




